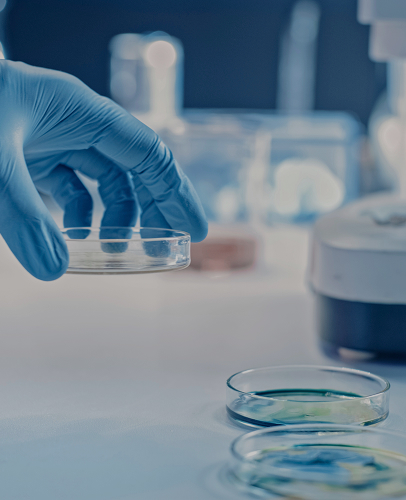

미래 첨단 글로벌 바이오 산업을 이끌어 나가는 차세대 특화 인재 양성

AI 및 디지털 기반 바이오의약품 제조공정 교육 콘텐츠 신설 및 필수화
디지털 트윈 기반 가상 공정환경 및 스마트 제조 시뮬레이션 실습 강화
산업체의 공정 제어 모델링 및 예측기술을 반영한 실습 중심 교과과정 개편

현장 공정 문제 중심의 PBL 및 캡스톤 프로젝트 운영 강화
실시간 공정데이터를 활용한 분석 및 AI 기반 품질·공정이상 탐지 실습 교육
산업체 공정 시나리오를 반영한 실습형 교과 설계 및 평가체계 운영

공정-품질-데이터-공학의 디지털 융합 교육과정 신설 및 운영
데이터 처리 및 공정 피드백이 연계된 통합형 실습 환경 구축
AI 기반 바이오의약품 제조공정 데이터 분석 및 실시간 품질예측 교육 구축

PAT, RTQC 기반 실시간 품질 분석 및 관리 교육내용 도입
공정 위험성 평가(FMEA), 품질이탈 대응 등 산업체 품질 이슈 중심의 실습 교육
케이스 스터디 기반 품질 평가 및 보고서 작성 실무 교육 강화

산업체 직무 요구를 반영한 현장 기반 프로젝트 및 교과 운영
전공 간 공동 커리큘럼 및 교과목 개발을 통한 전공 융합형 교육 운영
학내 연구소와 연계한 공동 실습환경 구축으로 실전형 교육 플랫폼 운영

